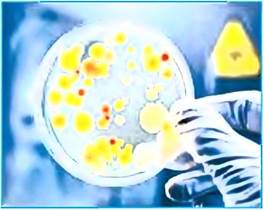

Учебник БИОЛОГИЯ 7 класс - Лисов Н. Д. 2017 год
Бактерии - древнейшие организмы на Земле - БАКТЕРИИ
Когда мы слышим о бактериях, то чаще всего представляем себе больное горло или десны, несмотря на то что только небольшая часть бактерий вызывает заболевания. Большинство же этих организмов выполняет другие важные функции.
С бактериями мы начинаем контактировать с первых часов жизни. Многие из них постоянно живут на поверхности кожи человека. Еще больше их на зубах, деснах, языке и стенках ротовой полости. Во рту живет больше бактерий, чем людей на Земле! Но самое большое их количество обитает в кишечнике — до 5 кг у взрослого человека.
Бактерии — мельчайшие живые организмы, обладающие клеточным строением. Они могут быть одно- или многоклеточными. Бактерии можно увидеть только в микроскоп, поэтому их называют микроорганизмами. Микроорганизмы изучает наука микробиология. Раздел микробиологии, изучающий бактерии, называется бактериологией.
Из этой главы вы узнаете:
• о бактериях, их строении и жизнедеятельности;
• какую роль играют бактерии в природе;
• какую пользу и вред приносят бактерии человеку;
• о цианобактериях и их функциях в экосистемах.
Вы научитесь:
• использовать полученные знания для профилактики бактериальных заболеваний.
§ 4. Бактерии — древнейшие организмы на Земле
Распространение и условия жизни бактерий. Бактерии встречаются везде: в воде, почве, воздухе, в тканях растений, телах животных и человека. Они живут там, где находят достаточно пищи, влаги и благоприятную температуру (10 — 40 °С). Большинству из них необходим кислород. Есть также бактерии, которые живут в горячих источниках (с температурой 60 — 90 °С), экстремально соленых водоемах, в жерлах вулканов, глубоко в океанах, куда не проникает солнечный свет. Даже в самых холодных регионах (Антарктике) и на высоких горных вершинах живут бактерии.
В разных местах встречается различное количество бактерий. Меньше всего их в воздухе, особенно в природных условиях. А в местах скопления людей, например, в кинотеатрах, на вокзалах, в классах, их значительно больше. Поэтому необходимо часто проветривать помещения.
В водах рек, особенно вблизи больших городов, бактерий может быть очень много — до нескольких сотен тысяч в 1 мм3. Поэтому нельзя пить сырую воду из открытых водоемов. Очень много бактерий в воде морей и океанов.
Еще больше бактерий в почве — до 100 млн в 1 г гумуса (плодородного слоя почвы).
Многообразие форм и строение бактерий. Как вы знаете, бактерии очень маленькие организмы. Самые большие бактерии можно увидеть под световым микроскопом.
Для знакомства с самыми маленькими требуется электронный микроскоп (рис. 7).

Рис. 7. Бактерии под микроскопом: световым (слева) и электронным (справа)
Если культивировать (выращивать) бактерии на питательной среде в благоприятных условиях, они очень быстро размножаются и образуют колонии до 4 млрд клеток. Колонии бактерий определенных видов имеют характерные очертания и окраску (рис. 8).
Рис. 8. Колонии бактерий на питательной среде в чашке Петри
По виду колоний можно установить наличие определенных бактерий в том или ином материале.
Научные открытия. Первым увидел и описал бактерии голландский естествоиспытатель Антони ван Левенгук (1632 — 1723). Он научился шлифовать стекла и изготавливать линзы. Левенгук изготовил более 400 микроскопов и открыл мир микроскопических организмов — бактерий и протистов.

Большинство бактерий, которые населяют наш дом и наше тело, имеют форму шариков, палочек и спиралей. Шаровидные бактерии носят название кокки, палочковидные — бациллы, спиралевидные — спириллы (рис. 9).

Рис. 9. Формы бактериальных клеток
Некоторые бактерии образуют цепочки, располагаясь вплотную друг к другу. Рассмотрите строение бактериальной клетки на рисунке 10. Она включает цитоплазму, окруженную цитоплазматической мембраной и клеточной оболочкой (клеточной стенкой). Оболочка придает бактерии определенную форму и служит защитой от неблагоприятных условий.

Рис. 10. Строение бактериальной клетки
Дополнительную защиту многим бактериям дает слизистый слой, расположенный с наружной стороны оболочки. Поверхность клетки бактерии покрывают многочисленные ворсинки, которые представляют собой полые выросты цитоплазматической мембраны. Некоторые бактерии имеют один или несколько нитевидных жгутиков.
Главное отличие бактерий — отсутствие ядра, т. е. они — прокариоты. Именно на этом основании их выделяют в отдельное царство. Ядерный материал у бактерий — бактериальная хромосома: она несет наследственную информацию.
Питание бактерий. Большинство бактерий являются гетеротрофами. Они потребляют готовые органические вещества. Пищей им служат живые и мертвые организмы, продукты питания человека, сточные воды и т. д.
Одни гетеротрофные бактерии используют органические вещества мертвых тел или выделений живых организмов. Это сапротрофы (от греч. сапрос — гнилой и трофос — питание). Другие питаются органическими веществами живых организмов. Это паразиты. Паразитами являются болезнетворные бактерии: дифтерийная и туберкулезная палочки, сальмонелла и др.
Существуют также автотрофные бактерии. Они способны образовывать органические вещества из неорганических (углекислого газа, воды, сероводорода и др.). У автотрофных фотосинтезирующих бактерий в клетках содержится бактериальный хлорофилл, с помощью которого они под действием солнечной энергии образуют органические вещества.
Размножение бактерий. Бактерии размножаются путем деления. При этом из одной материнской клетки образуются две дочерние клетки, похожие на материнскую. При благоприятных условиях (достаточном питании, влажности и температуре от 10 до 30 °С) бактерии могут делиться каждые 20 — 30 мин, поэтому их число очень быстро возрастает.
Движение бактерий. Некоторые бактерии двигаются с помощью жгутиков. Основание жгутика вращается, и он как бы ввинчивается в среду, обеспечивая передвижение бактерии. Большинство же бактерий передвигаются пассивно: одни с помощью потоков воздуха, другие — по течению воды. Так осуществляется их распространение.
Спорообразование. В неблагоприятных условиях (при недостатке пищи, влаги, резких колебаниях температуры) бактерии могут превращаться в споры. Цитоплазма вблизи бактериальной хромосомы уплотняется. Вокруг нее образуется очень прочная оболочка. Образовавшиеся таким путем споры могут существовать сотни лет (рис. 11).

Рис. 11. Бактериальные споры
При помощи ветра, животных или другим способом споры могут распространяться на большие расстояния. Когда споры попадают в благоприятные условия, их прочная оболочка разрушается. и из споры развивается новая бактерия.
Выводы.
Бактерии — одноклеточные или объединенные в колонии живые организмы, которые не имеют ядра.
Большинство бактерий являются гетеротрофами, но есть и автотрофы.
Размножаются делением.
При наступлении неблагоприятных условий некоторые бактерии образуют споры.
1. Какие условия необходимы для жизни бактерий? 2. Как широко распространены бактерии в природе? Перечислите основные места обитания бактерий. 3. Каковы особенности строения бактериальной клетки? 4. По какому признаку бактерии выделяют в самостоятельную группу организмов? 5. Какие способы питания характерны для бактерий? 6. Как бактерии переносят неблагоприятные условия?
При благоприятных условиях клетки бактерии кишечной палочки могут делиться каждые 20 мин. Рассчитайте, какое количество бактерий образуется от одной исходной клетки через 2 ч; через 5 ч.